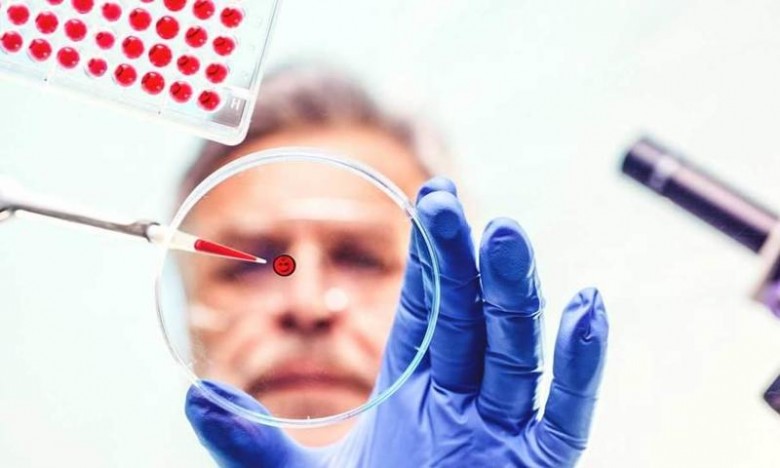
thumb (12)

السرطان مرض العصر والشغل الشاغل للعلماء. وفي جديد الطب، فإنه يتمّ حاليًّا التوجه إلى منع وصول الدم إلى الأورام السرطانية، لشلّ قدرة الخلايا على غزو الأنسجة المجاورة، وبالتالي انتشار المرض.
"سيدتي نت" التقى استشاري جراحة الأوعية الدموية والقسطرة الدكتور حافظ البلوي، فتحدّث حول هذه الطريقة الجديدة، قائلًا:
"إنّ الورم السرطاني يحتاج للتغذية بالدم، حتى ينمو وينتشر ويعتمد في البداية على الأوعية الدموية الطبيعية في العضو المصاب. وفي العديد من الحالات عندما يصل حجم الورم السرطاني الى ١-٢ ملم يقوم بتحويل استراتيجيته من الاعتماد على أوعية العضو المصاب، إلى تكوين أوعية دموية إضافية خاصة به، للحصول على تغذية أكبر تتناسب مع ازدياد حجمه وانتشاره".
وحول علاج السرطان من خلال مثبّطات نمو الأوعية الدموية، يقول الدكتور البلوي:"تقوم الخلايا السرطانية، في عدد كبير من الأورام، بإنتاج بروتين يطلق عليهVEGF، وهذا البروتين يتصل بالحسّاسات الخاصة المبطّنة للأوعية الدموية بالعضو المصاب، وبالتالي حثّها على النمو والتكاثر بشكل أسرع وأكبر، وحصول الورم على تغذية أكبر تتناسب مع ازدياد حجمه وانتشاره".
وتكشف دراسات وأبحاث جديدة الآتي:
1. بعد الكثير من البحوث العلمية في مجال محاربة السرطان، واكتشاف هذه الخاصية الأساسية لنمو وانتشار الورم السرطاني، تتكثف الدراسات حاليًّا على إيجاد طريقة لإيقاف هذه الخطوة، وبالتالي إيقاف نمو الورم.
2. توصل الباحثون إلى إيجاد عقاقير عدة تساهم في تعطيل هذا الجزء الأساسي من دورة نمو الورم منها:Anti angiogenesisالعقار المضادّ لإنتاج بروتين VEGF المسؤول عن نمو الأوعية الدموية في الورم السرطاني.
3. أثبت هذا العلاج فاعليته في تحجيم ومنع انتشار الكثير من أنواع الأورام السرطانية، ويأمل الأطباء بالمزيد من الأبحاث في هذا المجال، لفتح باب الأمل في علاج مرضى السرطان.
المصدر: وكالات